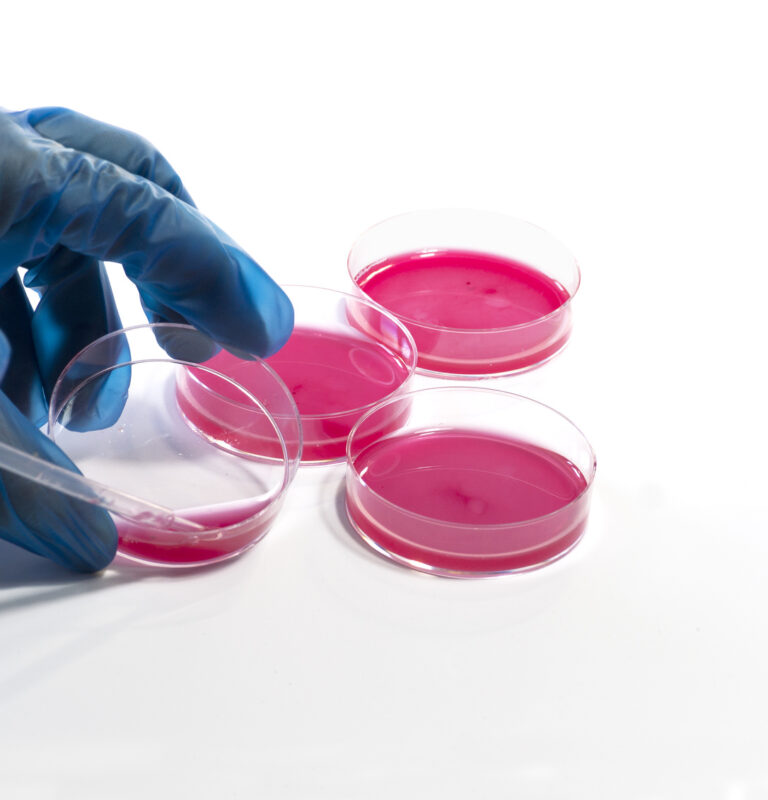

You may know that a stem cell is powerful in part because of its potential to develop into various body cells....
Medical researchers studying the effects of fruit and vegetable consumption on the body have arrived at differ...
Everyone knows that long work hours and intense periods of stress can make it difficult for us to function eff...
If the body ever becomes imbalanced, restoration of proper chemistry is critical to a strong immune system and...
One of the primary causes of pain is restriction within your soft tissues, which can be improved through thera...
A method that is often used to treat sports injuries is kinesiology taping, a.k.a. kinesio taping (KT). This s...
A study conducted at The Miriam Hospital – a teaching affiliate of Brown University – is one of the first...
A group of researchers from two organizations – Columbia University and the New York Stem Cell Foundation (N...
The onset of chronic pain from a car accident injury is not always evident directly following the event. In ma...
Physical therapy is used to restore the strength and fluidity of the body following a knee injury. This form o...